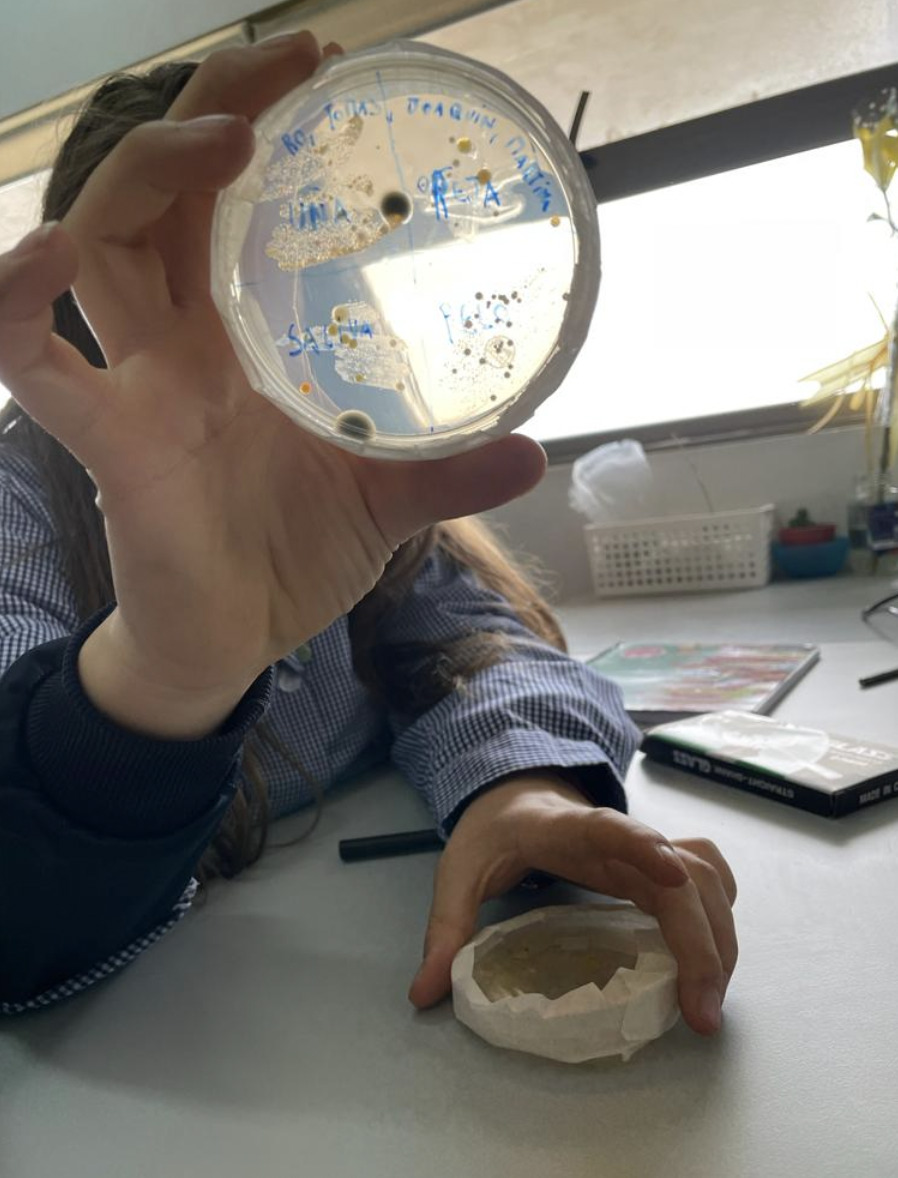

LABORATORIO ITINERANTE PARA TODOS
Contribuir como institución a la formación de científicos jóvenes
¡Así se vivió el proyecto!
El proyecto
Según la UNESCO, la ciencia nos ayuda a solucionar los problemas de la vida cotidiana y nos ayuda a dar respuesta a los misterios que existen en la humanidad. Es decir, nos abre la puerta a todo el conocimiento, y es por este motivo que buscamos impulsar el trabajo de investigación, potenciar las habilidades, capacidades y competencias de nuestros estudiantes.
Para vincular a los jóvenes con las tres ciencias, queremos implementar este "laboratorio itinerante", que permitirá llevar la ciencia a la sala, entregandoles la posibilidad de poner a prueba sus hipótesis, experimentar, observar y sacar conclusiones desde la vivencia pura, en la misma sala de clases, de manera comoda y segura. Tenemos plena convicción que el aprendizaje entre pares, genera un aprendizaje real y activo, que generará aprendizajes significativos.
Solo necesitamos un carro acondicionado para ser transportado dentro del colegio, que pueda llevar un kit de estudio para biología (mitosis y microbios), un kit para física (eclipses y dinámica) y un kit para química (reacciones redox y química de los alimentos), además de diversidad de experimentos.
Mis estudiantes
Mis estudiantes son muy curiosos, les gusta realizar preguntas, inventar cosas, buscar ideas nuevas para solucionar problemas. Vienen de realidades muy distintas, algunos con un alto conocimiento, pero la mayoria de ellos está aprendiendo y conocinedo diversas cosas en el colegio.
A muchos les motiva el área de las ciencias, lo que hace que se sientan atraidos por áreas como salud, investigación, ciencias básicas.
Estudiantes que creen en sus profesores, por lo que se suman a proyectos, se sienten agradecidos y comprometidos, trabajan con empeño y siempre con buena voluntad.
Costos
| Proveedor | Materiales | Costo unitario | Cantidad | Costo total |
|---|---|---|---|---|
| Bioquimica | Kit Mitosis | $76.055 | 1 | $76.055 |
| Bioquimica | Kit Química de los alimentos | $101.058 | 1 | $101.058 |
| Bioquimica | Kit Oxido Reducción | $207.357 | 1 | $207.357 |
| Bioquimica | Kit Eclipse | $92.916 | 1 | $92.916 |
| Bioquimica | Kit Escolar Microbios | $186.490 | 1 | $186.490 |
| Bioquimica | Kit Dinámica | $157.794 | 1 | $157.794 |
| Bioquimica | Kit de Experimentos 6 meses | $92.234 | 1 | $92.234 |
| Sodimac / Homy | Carrito Organizador | $26.590 | 1 | $26.590 |
| Despacho | $37.500 | |||
| Medio de pago ? | $11.757 |
| Fondo de reserva ? | $10.000 |
| TOTAL El proyecto | $999.751 |
| * El costo total del proyecto incluye los costos de proveedores, los costos de medios de pago y de administración. | |


Profe Angélica
Zurita Cisternas
Mi nombre es Angélica Zurita Cisternas, de primera profesión Química Industrial, y con los años opte por el cambio a Profesora de Química en Enseñanza Media.
Trabajo en el Liceo Bicentenario Simón Bolívar hace 9 años, muy feliz con mis estudiantes y con mis colegas. Es muy gratificante ver el desarrollo de los jóvenes, como llegan a nuestras aulas a los 14-15 años y como forjan su camino hasta salir del colegio con 17 o 18 años. Ser parte de su formación ha enriquecido mi quehacer docente, verlos desarrollados como profesionales, aún más.
De a poco hemos ido forjando una cuna de investigadores jovenes, hemos participado desde el año 2019 en el Concurso Nacional de Ciencias, Innovación y Tecnología del Museo de Historia Natural de Valparaiso, obteniendo el año 2021 el Primer Lugar Nacional.
Ser parte de la transformación de mis estudiantes es mi motor, ayudar en la formación de mentes creativas, críticas, innovadoras y amigables con el medio ambiente, es mi bandera de lucha.